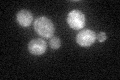
YEL043W
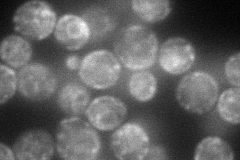
YEL043W
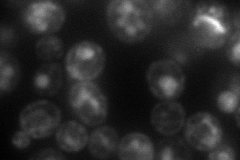
YEL043W
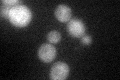
YEL043W

View description
Predicted cytoskeleton protein involved in intracellular signalling based on quantitative analysis of protein-protein interaction maps; may interact with ribosomes, based on co-purification studies; contains fibronectin type III domain fold
Localization:
Intensity:
Fold change:
Significance:
-
C’ GFP library in SD
ER30.46 -
N' NOP1pr-GFP in SD
ER,punctate93.1194 -
N' TEF2pr-mCherry in SD
ER,vacuole72.0452 -
N' NATIVEpr-GFP in SD

ambiguous,ER24.2738 -
N' TEF2pr-VC and Cyto-VN in SD

#N/A0 -
C’ GFP library in SD+DTT
ER25.210.82No -
C’ GFP library in SD+H2O2

ER30.671No -
C’ GFP library in Starvation Media

ER21.710.71Yes -
C’ GFP library on the background of Pup2-DaMP

N/A -
C’ GFP library on the background of CCT mutant

N/A0N/AYes
